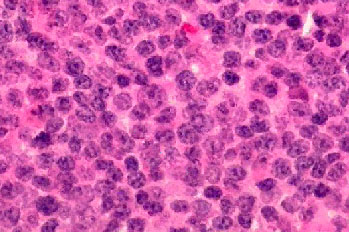

A
45-year-old man presented with a red lesion in his right eye of 6-month
duration which got progressively larger. He was treated by his GP for conjunctivitis
but without improvement. The lesion was painless. A conjunctival
biopsy was performed under local anaesthesia.

Appearance of the right eye.

Histology of the conjunctival biopsy.
1. What is the most likely diagnosis?
2. What is the most common origin
for the cells seen in the histology?
3. Name four investigations you would
order for this patient.
4. What is the risk of systemic
involvement compared with similar lesion
affecting the
eyelid or orbit (lower, similar or higher risk)?
5. Suggest two treatment options?
|